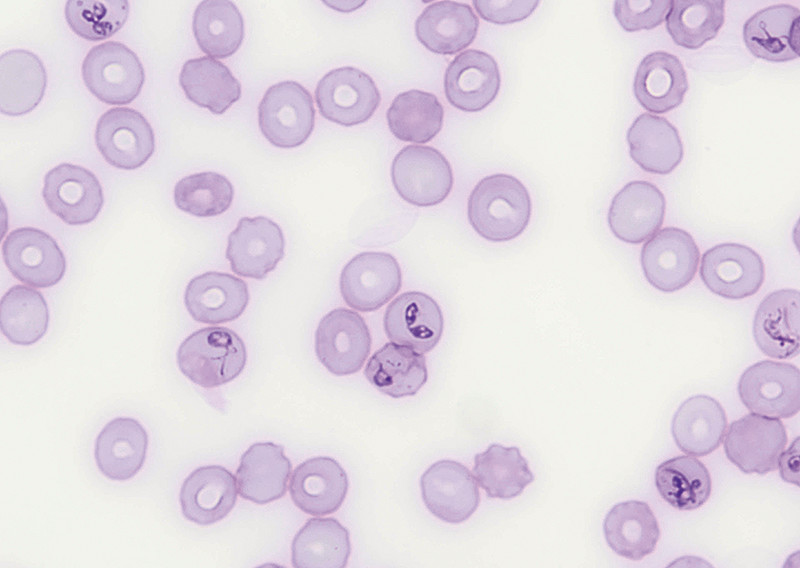

Inhalt

Die Babesiose des Hundes gehört weltweit zu den bedeutendsten Blutparasitosen und zählte lange zu den typischen Reiseerkrankungen, sie tritt jedoch bei Hunden in Zentraleuropa zunehmend auch autochthon auf. Die verschiedenen Babesien-Arten sind gemeinhin an unterschiedliche Arten von Zecken adaptiert. Die Parasiten befallen die Erythrozyten und führen je nach Parasitendichte zu einer mehr oder minder ausgeprägten Hämolyse. Eine Infektion kann bei Hunden mit einer erheblichen Morbidität und Mortalität einhergehen, wobei die klinischen Anzeichen und Pathogenese ähnlich denen der Malaria des Menschen sind. Daher wird die Krankheit auch heute noch zuweilen als „Hundemalaria“ bezeichnet [4, 5, 6]. Hunde sind eines der vielen Ziele der zahlreichen Babesien-Spezies. Die Zecken treten hierbei sowohl als Vektor als auch als Reservoir auf [1]. Ferner ist bereits von einer vertikalen Übertragung von Babesia canis bei Hunden berichtet worden.
Erreger
Anfänglich wurden Babesien entsprechend ihrer mikroskopisch im Blutausstrich erkennbaren Morphologie innerhalb der Erythrozyten als „große“ Formen wie Babesia (B.) canis (Merozoiten-Größe 4 – 5 µm) und „kleine“ Formen wie B. gibsoni (Merozoiten-Größe 1 – 2 [3] µm) klassifiziert [7]. Erst später wurden (Unter-)Arten von großen und kleinen Babesien eingeführt. Diese unterscheiden sich bezüglich Morphologie, Zecken-Vektoren, geografischer Verteilung und Pathogenität.
Erst mit der Einführung molekularer Phylogenie-Analysen zur Klärung der evolutionären Verwandtschaftsverhältnisse von Organismen wurden folgende Subspezies als eigenständige Spezies klassifiziert: B. canis, B. rossi und B. vogeli. Zudem wurden 3 kleine, beim Hund klinisch relevante Babesien beschrieben: B. gibsoni, B. vulpes [10, 11] und B. conradae [12].
In den letzten Jahren erlaubten molekulare Verfahren die Identifikation weiterer für den Hund infektiöser Spezies von Babesien, sodass derzeit mindestens 9 genetisch unterschiedliche Arten bekannt sind. Ergänzend wurde u. a. eine weitere „große“ Form der Babesien-Spezies namens B. bigemina in North Carolina (USA) beschrieben [13].
Übertragung und andere Faktoren
Babesien können vertikal und über direkten, vektorunabhängigen Kontakt wie Blut und Speichel (insbesondere bei B. gibsoni) übertragen werden. Eine Besonderheit von Babesia spp. liegt in den Möglichkeiten der Erregerübertragung von einem Entwicklungsstadium der Zecke zum nächsten (transstadial) oder zu etwa 10% transovariell auf die eigenen Nachkommen. Die vertikale Übertragung sorgt für eine lange Persistenz in einer Zeckenpopulation, auch wenn die Zecken in keinem Stadium an einem geeigneten Wirt saugen [40]. Die Übertragungszeit von Babesien beim Hund ist abhängig vom Geschlecht der Zecke und beträgt nach dem Festsaugen wenige Stunden bis ca. 2 Tage. Die Inkubationszeit wird allgemein mit 7 – 20 Tagen p. i. angegeben, kann jedoch je nach Art und Stammvirulenz variieren [41, 42].
Hinsichtlich der „großen“ Babesien-Arten ist B. canis in den meisten zentraleuropäischen Ländern diagnostiziert worden. Dies hängt vornehmlich mit der Abhängigkeit von seinem Hauptvektor, der Bunt- oder Auwaldzecke (Dermacentor reticulatus, [Abb. 1]) ab [43], die kältere Temperaturen toleriert, jedoch ein warmes und feuchtes Klima für ihre Entwicklungs- und Reproduktionszyklen bevorzugt [44, 45, 46]. Die adulte Zecke parasitiert an Hunden, während sich juvenile Individuen (Larven und Nymphen) an wilden Nagern ernähren und endophil leben. Zu den beliebtesten Habitaten zählen Wegränder und Felder in der Nähe von Wäldern [47]. Der globale Klimawandel, milde Winter und früh einsetzendes Tauwetter zeigen einen direkten Effekt auf die Aktivität der Zeckenpopulationen und das Überleben der Wirtspopulation (Nagetiere), die sich entsprechend in der Zahl klinischer Infektionen mit Babesien widerspiegelt [48].

Babesia vogeli spielt als Erreger bei der Betrachtung Europas hauptsächlich in Südeuropa eine Rolle, die Praxisrelevanz in Deutschland bleibt fraglich. Eine Übertragung erfolgt durch die Braune Hundezecke (Rhipicephalus sanguineus, [Abb. 2]). Der Erreger führt häufig nur zu geringen Antikörpertitern und gilt für adulte Hunde als schwach virulent, kann aber bei prädisponierenden Faktoren (jungen Hunden, Immunsuppression) auch einen schweren Verlauf nehmen.
Kleine-Babesien-Spezies wurden in verschiedenen Ländern Europas diagnostiziert. Berichte von Infektionen mit B. gibsoni stammen vor allem aus Süd- und Osteuropa sowie einzelne klinische Fallberichte aus Deutschland [48, 49], wobei auch hier R. sanguineus neben Haemaphysalis (H. longicornis) als Zeckenvektor zugeordnet wird [50].

Zoonose
Bei der humanen Babesiose handelt es sich um eine seltene Erkrankung, bei der insbesondere 2 humanpathogene Babesien-Spezies beteiligt sind [51]: B. divergens (bei europäischen Rindern vorkommend) und B. microti (parasitiert an kleinen Nagetieren in den Vereinigten Staaten). Beide werden über den Gemeinen Holzbock (Ixodes ricinus) übertragen. Zudem gibt es vereinzelte Berichte von Varianten der genannten zoonotischen Spezies in Europa [52]. Infektionen mit B. divergens können je nach Immunstatus der erkrankten Person einen schweren klinischen Verlauf nehmen oder bei einem immunkompetenten Patienten mit milden bis subklinischen Symptomen auftreten [52]. Infektionen mit B. canis und B. gibsoni werden nicht als Zoonosen für den Menschen angesehen [51].
Prädispositonen
Hunde jedes Alters und jeder Rasse können an Babesiose erkranken. Eine größere Anzahl zuverlässiger Studien fehlt jedoch. Eine Studie aus Südafrika zeigte, dass insbesondere Gesellschafts- und Begleithunde ein niedrigeres Risiko aufwiesen, an Babesiose zu erkranken [54]. Eine eindeutige Erklärung hierfür gibt es nicht, jedoch wird über eine geringere Vektorexposition aufgrund der unterschiedlichen Haltungsbedingungen oder eine geringere genetische Empfindlichkeit diskutiert. Ältere Studien zeigten eine höhere Anfälligkeit für eine Infektion mit B. canis für den Deutschen Schäferhund und Ungarischen Hirtenhund [55] sowie eine kleine Anzahl anderer Rassen. Weitere Berichte über eine mögliche Prädisposition anderer Babesien bestehen u. a. für B. vogeli bei Greyhounds und B. gibsoni bei American Pit Bull Terriern [23].
Verbreitung
In Südosteuropa überlappt die Verteilung von B. canis teilweise mit der von B. vogeli. Nach Duh et al. [14] ist der Erreger mit der größten klinischen Relevanz für den Hund zum aktuellen Zeitpunkt jedoch B. canis , was auch für Zentraleuropa zutrifft. Durch Nachweise in Ixodes-Zecken und Füchsen konnte belegt werden, dass kleine Formen wie etwa B. vulpes [15] ebenfalls an Bedeutung gewinnen [16]. Es bleibt jedoch zu klären, ob diese Funde auch für Hunde eine Relevanz aufweisen [17].
Die geografische Verteilung von Babesien ist stark schwankend und überwiegend abhängig von der Verteilung der übertragenden Zecken. Wie Barutzki et al. [30] belegt haben, wird die kanine Babesiose zunehmend in Deutschland und in der Schweiz endemisch [10, 17, 25, 31, 32, 33, 34]. Diese Ausbreitung scheint das Resultat multipler Faktoren zu sein. Hierzu zählen der Import von Hunden insbesondere aus süd- und osteuropäischen Ländern [35, 36, 37] und eine zunehmende Dichte an infizierten Zecken, die durch veränderte Umweltfaktoren, wie z. B. klimatische Veränderungen [16, 38, 39], neue geeignete Biotope zur Ansiedelung gefunden haben.
Symptome
Die Symptome hängen vom Verlauf der Infektion (perakut, akut, subakut, chronisch oder latent) ab. In der Regel verläuft die Erkrankung akut und führt, wenn sie nicht rechtzeitig erkannt und behandelt wird, bis zu Multiorganversagen und Tod [57]. Wichtige Faktoren, die zu der großen Variabilität der klinischen Erscheinungsbilder führen, sind [25, 58]:
- Babesien-Spezies
- Immunstatus
- Co-Infektionen
- Begleiterkrankungen
- Splenektomie
Perakute oder akute Infektion
Bei einer perakuten oder akuten Infektion treten unspezifische klinische Erscheinungen auf, wie z. B. hohes Fieber (bis 42 °C), starker Durst, Appetitlosigkeit, Mattigkeit und schneller Konditions- und Gewichtsverlust. Im weiteren Verlauf kommt es durch den Befall und die Zerstörung der roten Blutkörperchen zu Anämie, Lymphknotenschwellungen, Splenomegalie und Ikterus. Charakteristisch sind eine Hämoglobinurie und Bilirubinurie oftmals mit einer Bilirubinämie und Proteinurie, ausgelöst durch eine intravasale Hämolyse. Seltener können in Haut und Schleimhäuten Petechien und Ekchymosen zu erkennen sein. Klinisch äußert sich die akute kanine Babesiose in einer unkomplizierten (ohne Organdysfunktion) oder komplizierten Verlaufsform mit (Multi-)Organdysfunktion, z. B. Niere, Leber, Lunge etc. [60], sowie auch Koagulopathien und SIRS (systemic inflammatory response syndrom) [61, 62]. Sofern auch das zentrale Nervensystem betroffen ist, sind Bewegungsstörungen durch partielle Lähmungen sowie epileptiforme Anfälle möglich.
Chronische Infektion
Chronische Infektionen sind v. a. mit kleinen Babesien beschrieben und äußern sich durch geschwächte und abgemagerte Tiere mit intermittierendem Fieber, Apathie und Anämie über Monate. Insbesondere Importhunde können ohne Behandlung v. a. bei Infektionen mit B. canis und B. vogeli auch eine subklinische Form bei wieder normalem Blutbild entwickeln. Zudem kann bei diesen Hunden die Infektion durch verschiedene Faktoren reaktiviert werden, z. B. durch eine immunsuppressive Therapie, eine Splenektomie oder andere immunsupprimierende Faktoren wie chirurgische Eingriffe oder Krankheiten [23, 63].
Diagnostik
Die mikroskopische Untersuchung eines nach Giemsa gefärbten Blutausstrichs ist als erster Screening-Schritt ein nützliches Diagnostikum in der tierärztlichen Praxis, das jedoch meist nur in der akuten Phase der Infektion (ca. ab dem 5. Tag p. i.) gelingt [70, Abb. 3]. Frisches Kapillarblut aus der Peripherie (z. B. Ohrrand) oder eine Buffy-Coat-Präparation eignen sich besonders gut zum Parasitennachweis, da befallene Erythrozyten in Kapillaren sequestrieren bzw. Babesien dazu tendieren, eher Retikulozyten als reife Erythrozyten zu befallen. [25, 26, 71]
Die Diagnostik mittels indirekter serologischer Tests bedient sich quantitativer Methoden zum Antikörper-Nachweis wie IFAT (indirekte Immun-Fluoreszenz-Antikörper-Tests) oder ELISA (Enzyme-linked Immunosorbent Assay). Bei experimentell infizierten Hunden konnten spezifische Antikörper ab Tag 14 p. i. nachgewiesen werden [73]. Ein weiteres anwendbares Verfahren zum Nachweis von B. canis im Serum ist die Massenspektrometrie.
Die Vorteile der Serologie liegen in der Bestimmung der Antikörper-Titer und somit der Möglichkeit, diese quantitativ zu bewerten. Auch bei Fällen mit niedriger oder intermittierender Parasitämie und bei chronisch-latenten Infektionen ist der Einsatz der Serologie von Nutzen. Von Bedeutung ist daher die Einsendung in spezialisierte Labore, die serologische Tests regelmäßig durchführen und in der Lage sind, einen definitiven Titer zu bestimmen [75]. Dennoch sollte in den meisten Fällen die Entscheidung für eine spezifische Therapie nicht auf dem Ergebnis der serologischen Tests beruhen, da der Zeitraum bis zum Erhalt der Auswertung häufig zu lange ist.
Ein wichtiger Bestandteil der Babesien-Diagnostik beim Hund ist die als „Goldstandard“ angesehene PCR. Als Probenmaterial dient idealerweise eine periphere Blutprobe gepuffert mit EDTA oder eine Zecke (noch am Tier vorhanden oder vom Tierbesitzer abgesammelt). Darüber hinaus kann auch Milzgewebe nützlich sein, obwohl die Gewinnung dieser Art von Probenmaterial eines deutlich invasiven Eingriffs bedarf und somit selten Verwendung findet [66].
Der Direktnachweis mittels PCR ist deutlich sensitiver als die mikroskopische Untersuchung eines gefärbten Blutausstrichs [72]. Außerdem kann der DNA-Nachweis eines spezifischen Pathogens bei entsprechender Klinik als Nachweis einer aktiven und somit auch fortbestehenden Infektion angesehen werden. Eine Stärke der PCR liegt darin, dass nachfolgend an einen positiven Babesien-PCR-Befund eine Unterscheidung der Babesien-Art etwa mittels artspezifischer Realtime-PCRs oder einer SSU-rDNA-Amplifikation mit anschließender Sequenzierung vorgenommen werden kann. Dies ist bei der Auswahl der Therapie wesentlich, denn große und kleine Babesien erfordern eine unterschiedliche Wirkstoffwahl. Bei chronisch infizierten Tieren kann die PCR Schwächen zeigen. Im Rahmen einer intermittierenden Parasitämie oder chronischen Infektion ist zwar in vielen Lokalisationen eine Erregerausbreitung zu erwarten, allerdings kann die Konzentration an Erreger-DNA im Blut sehr gering sein und die PCR daher ein negatives Ergebnis liefern.
Merke
Eine positive PCR ist beweisend für eine Infektion, eine negative PCR schließt jedoch eine Infektion niemals aus.
Labor
Je nach Babesien-Art können Unterschiede in den Laborwerten beobachtet werden [64]. Im Zuge der Parasitenproliferation wird SPA (Soluble Parasite Antigen) gebildet. SPA wirkt auf unterschiedliche Weise schädigend, indem es in die Gerinnungskaskade eingreift und zur Freisetzung von vasoaktiven Mediatoren oder Autoagglutination von Erythrozyten führt. Vasodilatation, Hypotension und Sequestration (Sludge-Phänomen) sind die Folgen. Zu den typischen Laborbefunden zählen insbesondere Anämien. Diese entstehen durch eine Kombination von intravasaler und extravasaler Hämolyse, die durch parasitär-bedingte Hämoglobin-Schädigung, erhöhte osmotische Fragilität der Erythrozyten und Aktivierung sekundärer immun-mediierter Prozesse ausgelöst wird [56]. Charakteristisch ist die Entstehung einer hämolytischen Anämie, die initial aregenerativ, normozytär und normochrom und später regenerativ, makrozytär und hypochrom verläuft.
Im Verlauf der Erkrankung können zudem eine sekundäre immunhämolytische Anämie mit positivem Coombs-Test und Sphärozyten sowie oftmals eine Leukopenie und später z. T. ausgeprägte Leukozytose mit Linksverschiebung und Neutropenie entstehen. Auch die Thrombozytopenie gehört zu den kennzeichnenden Laborveränderungen und variiert wie der Grad der Anämie zwischen mild und hochgradig.
Eine weitere Laborabweichung kann ein Anstieg der Leberenzyme (AST, ALT) infolge einer Hepatopathie sein. Bei Vorliegen einer Glomerulopathie können auch eine Azotämie sowie eine langanhaltende Hypalbuminämie (Hepato- und Glomerulopathie) und Hyperbilirubinämie beobachtet werden [66]. Abweichende Laborbefunde, die mit einer schlechten Prognose bei akutem Verlauf einer Babesiose in Zusammenhang zu stehen scheinen, sind neben Hinweisen auf eine verminderte Nierenfunktion [68, 69] auch [59]:
- mittelgradige Anämie
- hochgradige Thrombozytopenie
- geringgradige bis mittelgradige Leukopenie
- Hyperlaktatämie
- mittelgradige Hyperphosphatämie
- Triglyceridämie
- Hypoproteinämie
Behandlung
Vor Beginn einer Behandlung sollte mittels PCR anhand von EDTA-Blut differenziert werden, ob es sich um eine Infektion mit großen oder kleinen Babesien handelt. Dies ist von therapeutischer Relevanz, da kleine Babesien mit den handelsüblichen, normalerweise gegen B. canis wirksamen Medikamenten, nicht erfasst werden.
Infektion mit großen Babesien
Dieser Inhalt unterliegt den Bestimmungen gemäß Heilmittelwerbegesetz (HWG) und darf nur berechtigten Personen zugänglich gemacht werden. Bitte loggen Sie sich ein, um diesen Inhalt zu sehen.
Infektion mit kleinen Babesien
Kleine Babesien sind schwer zu behandeln, da es noch keinen Wirkstoff gibt, der eine komplette Parasitenelimination bewirkt. Dies hat zur Folge, dass Patienten auf die Therapie nicht ansprechen oder Rezidive entwickeln.
Dieser Inhalt unterliegt den Bestimmungen gemäß Heilmittelwerbegesetz (HWG) und darf nur berechtigten Personen zugänglich gemacht werden. Bitte loggen Sie sich ein, um diesen Inhalt zu sehen.
Unterstützende Therapie
Eine unterstützende Therapie ist bei moderaten bis schweren Babesiose-Infektionen notwendig und bedarf einer stationären Aufnahme.
Eine Bluttransfusion mit Erythrozyten-Konzentrat (alternativ: synthetischem Hämoglobin) kann bei einem akuten Infektionsverlauf mit hochgradiger Anämie (normalerweise bei einem Hämatokrit < 15% empfohlen und < 10% indiziert) und passenden klinischen Symptomen wie Tachykardie, Tachypnoe, Schwäche und Kreislaufkollaps unterstützend notwendig sein. Hunde mit DIC oder Koagulopathie benötigen ggf. eine Plasmatransfusion.
Eine intravenöse Flüssigkeitstherapie ist essenziell zur Aufrechterhaltung des Blutvolumens, der Perfusion von Endorganen und der Diurese, insbesondere bei Verdacht auf eine Nierenbeteiligung [13]. Da es nach der Verabreichung von Imidocarb, insbesondere in höheren Dosierungen und intramuskulärer Injektion, zu einer Steigerung der Aktivität der Plasma-Kreatinin-Kinase kommen kann, wird bei leichter Azotämie gleichzeitig eine Flüssigkeitssubstitution empfohlen [14].
Der Einsatz von Immunsuppressiva bei Hunden mit einer IMHA (immune mediated hemolitic Anemia) oder Thrombozytopenie wird kontrovers diskutiert, da diese immer in Verbindung mit der Infektion stehen.
Dieser Inhalt unterliegt den Bestimmungen gemäß Heilmittelwerbegesetz (HWG) und darf nur berechtigten Personen zugänglich gemacht werden. Bitte loggen Sie sich ein, um diesen Inhalt zu sehen.
Im Verlauf einer IMHA ist eine häufige und gefürchtete Komplikation die Thromboembolie. Die Entwicklung einer Lungenembolie ist hierbei eine der häufigsten Todesursachen. Eine entsprechende Thromboseprophylaxe mit einem Thrombozytenaggregationshemmer, z. B. Clopidogrel, kann zusätzlich indiziert sein [17].
Prophylaxe
Um das Risiko einer Infektion mit Babesien oder mit anderen durch Zecken übertragbaren Krankheiten zu vermindern, ist eine Zeckenprophylaxe ratsam. Allerdings ist dieser Ansatz der Prophylaxe durch die Möglichkeit der horizontalen Erreger-Übertragung einiger Babesien-Arten erschwert. Zu den horizontalen Übertragungsmöglichkeiten zählt die Bluttransfusion. Bei kleinen Babesien wird auch eine direkte Hund-zu-Hund-Übertragung (Bisswunden, Speichel) insbesondere bei Kampfhunden angenommen [22, 23].
Vektorprophylaxe
Für eine möglichst wirksame Vektorprophylaxe sind verschiedene Anti-Zecken-Mittel verfügbar. Ihre Wirksamkeit beruht auf verschiedenen Effekten:
- Repellent-Effekt: Der Parasit wird vom behandelten Wirt ferngehalten
- Anti-feeding-Effekt: Der Parasit wird davon abgehalten, den Wirt zu stechen
- Knock-down-Effekt: Der Parasit wird gelähmt
- Letal-Effekt: Der Parasit wird getötet
Neben täglicher adspektorischer Untersuchung und Entfernung vorhandener Zecken sind zur Zeckenbekämpfung eine Auswahl von Akariziden (Spot-On, Zeckenhalsbänder) mit oder ohne Repellent-Wirkung geeignet.
Zu den Akarizid-Halsbänder für Hunde mit Wirkung gegen Zecken und Zulassung in Deutschland und Österreich gehören z. B. Scalibor (Wirkstoff Deltamethrin, Wirkungsdauer ca. 5 – 6 Monate) oder Seresto (Wirkstoff Flumethrin/Imidacloprid, Wirkungsdauer ca. 7 – 8 Monate). Zudem gibt es eine Reihe von Spot-On-Produkten (Permethrin-haltige und Nicht-Permethrin-haltige Produkte), die sowohl zur Vorbeugung als auch zur Behandlung von Zecken eingesetzt werden. Das Präparat wird üblicherweise alle 4 Wochen auf das Tier aufgebracht und weist eine anhaltende akarizide Wirkung gegen Zecken auf, abhängig vom Akarizid kann die Wirkdauer jedoch gegen verschiedene Zeckenarten unterschiedlich sein.
Bei Reisen in endemische Gebiete (z. B. mediterrane Urlaubsländer, Ungarn) sollte eine Behandlung im 14-tägigen Rhythmus erfolgen.
Seit wenigen Jahren sind auch orale Anti-Zecken-Mittel als Kautablette für Hunde verfügbar. Es handelt sich hierbei um systemische Akarizide der Wirkstoffklasse der Isoxazoline. Aktuell sind 4 zugelassene Wirkstoffe – Afoxolaner, Fluralaner [28], Lotilaner und Sarolaner – als orale Anti-Zecken-Mittel (Wirkstoff Fluralaner auch als Spot-on) für den Hund erhältlich.
Je nach Produkt hält die Wirkung gegen Zecken unterschiedlich lange an (4 – 12 Wochen) und besitzt abhängig vom Wirkstoff eine Abtötungsgeschwindigkeit („speed of kill“, im Folgenden als SOK bezeichnet) bei Zecken zwischen 8 und 48 Stunden. Der SOK der Isoxazoline ist zudem davon beeinflusst, ob die Zecke vor Anwendung auf dem Tier war [27, 29].
Da die Babesiose eine unter Umständen lebensgefährliche Erkrankung darstellt, ist es wichtig, dass die Zeckenprophylaxe vor der ersten Exposition anfängt. Deshalb sind besonders schnell wirksame Akarizide mit repellierender Wirkung zu bevorzugen (Wirkstoffklasse der Pyrethroide z. B. Permethrin und Flumethrin), denn eine Zecke, die nicht zum Blutsaugen kommt, kann auch keine Krankheitserreger übertragen [26, 30]. Unter ungünstigen Bedingungen bieten auch Präparate mit Repellent-Effekt keinen 100%igen Schutz vor Übertragung von Infektionskrankheiten durch Ektoparasiten [27].
Merke
Die Zeckenprophylaxe sollte den gesamten Zeitraum abdecken, in dem Zecken aktiv sein können (in Zentraleuropa typischerweise von März bis Juni und von September bis November) und sich zudem nach dem jeweiligen Risikolevel (z. B. Gebiete mit hoher Zeckendichte, milde Winter) und Lebensstil des Hundes richten [26]. Dies bedeutet, dass in einigen Fällen zu einem ganzjährigen Zeckenschutz geraten werden sollte.
Fazit
Der Kenntnisstand über die kanine Babesiose hat sich insgesamt im Laufe der Jahre in Europa verbessert. Die Behandlung und der Behandlungserfolg bei den verschiedenen Babesien-Spezies unterscheiden sich stark. In der Regel gelten kleine Babesien als behandlungsresistenter als große Babesien. In vielen Fällen, insbesondere bei Hunden aus endemischen Gebieten, kann der Verlauf einer Babesiose-Infektion durch Co-Infektionen verkompliziert werden. Die Behandlungsmaßnahmen werden dadurch erschwert, dass geeignete Wirkstoffe zur Babesiose-Therapie in Deutschland nicht zugelassen sind und über eine Apotheke aus dem Ausland bezogen werden müssen. Die Präventionsmethode der Wahl in endemischen Gebieten ist die aggressive Zeckenprophylaxe.
Die Originalartikel zum Nachlesen:
(RG)
Teil 1 (bis einschließlich Labor):
- El-Bahnasawy MM, Khalil HH, Morsy TA. Babesiosis in an Egyptian boy acquired from pet dog, and a general review. J Egypt Soc Parasitol 2011; 41 (01) 99-108
- Babes V. Sur lʼhemoglobinurie bactérienne du boeuf. C R Acad Sci Ser III Sci Vie 1888; 107: 692-694
- Roncalli AR. The history of Italian parasitology. Vet Parasitol 2001; 98: 3-30
- Jacobson LS, Clark IA. The pathophysiology of canine babesiosis: new approaches to an old puzzle. J S Afr Vet Assoc 1994; 65 (03) 134-145
- Welzl C, Leisewitz AL, Jacobson LS. et al. Systemic inflammatory response syndrome and multiple-organ damage/dysfunction in complicated canine babesiosis. J S Afr Vet Assoc 2001; 72 (03) 158-162
- Clark IA, Jacobson LS. Do babesiosis and malaria share a common disease process?. Ann Trop Med Parasitol 1998; 92 (04) 483-488
- Patton WS. Preliminary report on a new piroplasm (Piroplasma gibsoni sp. nov.) found in the blood of the hounds of the Madras Hunt and subsequently discovered in the blood of the jackal Canis aureus. Bull Soc Pathol Exot 1910; 3: 274-280
- Schnittger L, Rodriguez AE, Florin-Christensen M, Morrison DA. Babesia: a world emerging. Infect Genet Evol 2012; 12 (08) 1788-1809
- Lack JB, Reichard MV, Van Den Bussche RA. Phylogeny and evolution of the Piroplasmida as inferred from 18S rRNA sequences. Int J Parasitol 2012; 42 (04) 353-363
- Baneth G. Reclassification of Theileria annae as Babesia vulpes sp. nov. Parasit Vectors 2015; 8: 207
- Zahler M, Rinder H, Schein E, Gothe R. Detection of a new pathogenic Babesia microti-like species in dogs. Vet Parasitol 2000; 89: 241-248
- Kjemtrup AM, Wainwright K, Miller M. et al. Babesia conradae sp. nov., a small canine Babesia identified in California. Vet Parasitol 2006; 138: 103-111
- Birkenheuer AJ. Detection and molecular characterization of a novel large Babesia species in a dog. Vet Parasitol 2004; 124(3 – 4): 151-160
- Duh D, Tozon N, Petrovec M. et al. Canine babesiosis in Slovenia: molecular evidence of Babesia canis canis and Babesia canis vogeli. Vet Res 2004; 35 (03) 363-368
- Baneth G, Cardoso L, Brilhante-Simoes P, Schnittger L. Establishment of Babesia vulpes n. sp. (Apicomplexa: Babesiidae), a piroplasmid species pathogenic for domestic dogs. Parasit Vectors 2019; 12: 129
- Hartelt K, Pluta S, Oehme R, Kimmig P. Spread of ticks and tick-borne diseases in Germany due to global warming. Parasitol Res 2008; 103 (Suppl. 01) 109-116
- Najm NA, Meyer-Kayser E, Hoffmann L. et al. A molecular survey of Babesia spp. and Theileria spp. in red foxes (Vulpes vulpes) and their ticks from Thuringia, Germany. Ticks Tick Borne Dis 2014; 5 (04) 386-391
- Brandao LP, Hagiwara MK, Myiashiro SI. Humoral immunity and reinfection resistance in dogs experimentally inoculated with Babesia canis and either treated or untreated with imidocarb dipropionate. Vet Parasitol 2003; 114: 253-265
- Boozer L, Macintire D. Babesia gibsoni: An emerging pathogen in dogs. Compendium on Continuing Education for the Practising Veterinarian–North American Edition 2005; 27 (01) 33-42
- Jefferies R, Ryan UM, Jardine J. et al. Blood, Bull Terriers and Babesiosis: further evidence for direct transmission of Babesia gibsoni in dogs. Aust Vet J 2007; 85: 459-463
- Jeagley TJ, Reichard MV, Hempstead JE. et al. Detection of Babesia gibsoni and the canine small Babesia ‚Spanish isolate‘ in blood samples obtained from dogs confiscated from dogfighting operations. J Am Vet Med Assoc 2009; 235: 535-539
- Birkenheuer AJ, Correa MT, Levy MG, Breitschwerdt EB. Geographic distribution of babesiosis among dogs in the United States and association with dog bites: 150 cases (2000–2003). J Am Vet Med Assoc 2005; 227: 942-947
- Birkenheuer AJ, Levy MG, Stebbins M. et al. Serosurvey of anti Babesia antibodies in stray dogs and American pit bull terriers and American staffordshire terriers from North Carolina. J Am Anim Hosp Assoc 2003; 39: 551-557
- Trotta M, Carli E, Novari G. et al. Clinicopathological findings, molecular detection and characterization of Babesia gibsoni infection in a sick dog from Italy. Vet Parasitol 2009; 165: 318-322
- Irwin PJ. Canine babesiosis: from molecular taxonomy to control. Parasit Vectors 2009; Suppl 1 (Suppl 1): S4
- Ayoob AL, Hackner SG, Prittie J. Clinical management of canine babesiosis. J Vet Emerg Crit Care (San Antonio) 2010; 20 (01) 77-89
- Mierzejewska EJ, Welc-Faleciak R, Bednarska M. et al. The first evidence for vertical transmission of Babesia canis in a litter of Central Asian Shepherd dogs. Ann Agric Environ Med 2014; 21 (03) 500-503
- Fukumoto S, Suzuki H, Igarashi I, Xuan X. Fatal experimental transplacental Babesia gibsoni infections in dogs. Int J Parasitol 2005; 35: 1031-1035
- Eckert J, Friedhoff KT, Zahner H, Deplazes P. Lehrbuch der Parasitologie für die Tiermedizin. Stuttgart: Enke; 2005: 57
- Barutzki D, Reule M, Scheunemann R. et al. Die Babesiose des Hundes. Dt Tierärztebl 2007; 55: 284-293
- Zahler M, Rinder H, Schein E, Gothe R. Detection of a new pathogenic Babesia microti-like species in dogs. Vet Parasitol 2000; 89 (03) 241-248
- Zahler M, Rinder H, Zweygarth E. et al. Babesia gibsoni of dogs from North America and Asia belong to different species. Parasitol 2000; 120 (04) 365-369
- Beck R, Vojta L, Mrljak V. et al. Diversity of Babesia and Theileria species in symptomatic and asymptomatic dogs in Croatia. Int J Parasitol 2009; 39 (07) 843-848
- Falkenö U, Tasker S, Osterman-Lind E, Tvedten HW. Theileria annae in a young Swedish dog. Acta Vet Scand 2013; 55: 50
- Hinaidy HK, Tschepper P. Babesia canis in a dog in Austria. Wien Tierärztl Mschr 1979; 66: 302-304
- Schwendenwein I. Canine babesiosis in Austria – review of clinical presentation, diagnosis and therapy with reference to four cases. Wien Tierärztl Mschr 1989; 76: 161-164
- Daugschies A. Import von Parasiten durch Tourismus und Tierhandel. Dtsch tierärztl Wschr 2001; 108: 348-352
- Heile C, Heydorn AO, Schein E. Dermacentor reticulatus (Fabricius, 1794) – Verbreitung, Biologie und Vektor von Babesia canis in Deutschland. Berl Münch Tierarztl Wochenschr 2006; 119(7 – 8): 330-334
- Janjić F, Sarvan D, Tomanović S. et al. A short-term and long-term relationship between occurrence of acute canine babesiosis and meteorological parameters in Belgrade, Serbia. Ticks Tick Borne Dis 2019; 10: 101273
- Deplazes P, Eckert J, von Samson-Himmelstjerna G, Zahner H. Lehrbuch der Parasitologie für die Tiermedizin. 3. Aufl.. Stuttgart: Enke; 2013
- Deplazes P, Staebler S, Gottstein B. Reisemedizin parasitärer Erkrankungen des Hundes. Schweiz Arch Tierheilk 2006; 148: 447-461
- Belton D. Import risk analysis: Babesia gibsoni in dogs (Canis familiaris) and dog semen. Wellington (NZ): Biosecurity Authority, MAF 2003.
- Karbowiak G. The occurrence of the Dermacentor reticulatus tick-its expansion to new areas and possible causes. Ann Parasitol 2014; 60 (01) 37-47
- Mehlhorn H. Light and electron microscopic study on developmental stages of Babesia canis within the gut of the tick Dermacentor reticulatus. J Parasitol 1980; 66 (02) 220-228
- Martinod S, Brossard M, Moreau Y. Immunity of dogs against Babesia canis, its vector tick Dermacentor reticulatus, and Ixodes ricinus in endemic area. J Parasitol 1985; 71: 269-273
- Uilenberg G. Babesia – a historical overview. Vet Parasitol 2006; 138(1 – 2): 3-10
- Rubel F, Brugger K, Monazahian M. et al. The first German map of georeferenced ixodid tick locations. Parasit Vectors 2014; 7: 477
- Hartelt K, Rieker T, Oehme RM. et al. First evidence of Babesia gibsoni (Asian genotype) in dogs in Western Europe. Vector Borne Zoonotic Dis 2007; 7: 163-166
- Teodorowski O, Kalinowski M, Winiarczyk D. et al. Babesia gibsoni Infection in Dogs – A European Perspective. Animals 2022; 12 (06) 730
- Chao LL, Liao HT, Ho TY, Shih CM. First detection and molecular identification of Babesia gibsoni from Rhipicephalus sanguineus ticks. Acta Trop 2017; 166: 356-362
- Homer MJ, Aguilar-Delfin I, Telford SR. et al. Babesiosis. Clin Microbiol Rev 2000; 13: 451-469
- Yabsley MJ, Shock BC. Natural history of Zoonotic Babesia: Role of wildlife reservoirs. Intern J Parasitol Parasit Wild 2013; 2: 18-31
- Kjemtrup AM, Conrad PA. Human babesiosis: an emerging tick-borne disease. Int J Parasitol 2000; 30: 1323-1337
- Mellanby RJ, Handel IG, Clements DN. et al. Breed and sex risk factors for canine babesiosis in South Africa. J Vet Intern Med 2011; 25: 1186-1189
- Hornok S, Edelhofer R, Farkas R. Seroprevalence of canine babesiosis in Hungary suggesting breed predisposition. Parasitol Res 2006; 99: 638-642
- Martinod S, Brossard M, Moreau Y. Immunity of dogs against Babesia canis, its vector tick Dermacentor reticulatus, and Ixodes ricinus in endemic area. J Parasitol 1985; 71 (03) 269-273
- Kraje AC. Canine haemobartonellosis and babesiosis. Compend Contin Educ 2001; 23: 310-318
- Solano-Gallego L, Capri A, Pennisi MG. et al. Acute febrile illness is associated with Rickettsia spp infection in dogs. Parasit Vectors 2015; 8: 216
- Eichenberger RM, Riond B, Willi B. et al. Prognostic markers in acute Babesia canis infections. J Vet Intern Med 2016; 30: 174-182
- Matijatko V, Torti M, Schetters TP. Canine babesiosis in Europe: how many diseases?. Trends Parasitol 2012; 28 (03) 99-105
- Milanović Z, Vekić J, Radonjić V. et al. Association of acute Babesia canis infection and serum lipid lipoprotein, and apoprotein concentrations in dogs. J Vet Intern Med 2019; 33: 1686-1694
- Schetters TP, Kleuskens JA, Van De Crommert J. et al. Systemic infl ammatory responses in dogs experimentally infected with Babesia canis; a haematological study. Vet Parasitol 2009; 162: 7-15
- Birkenheuer AJ, Levy MG, Breitschwerdt EB. Efficacy of combined atovaquone and azithromycin for therapy of chronic Babesia gibsoni (Asian genotype) infections in dogs. J Vet Intern Med 2004; 18: 494-498
- Miro G, Checa R, Paparini A. et al. Theileria annae (syn. Babesia microti-like) infection in dogs in NW Spain detected using direct and indirect diagnostic techniques: clinical report of 75 cases. Parasit Vectors 2015; 8: 217
- Vannier EG, Diuk-Wasser MA, Mamoun CB, Krause PJ. Babesiosis. Infect Dis Clin North Am 2015; 29: 357-370
- Solano-Gallego L, Baneth G. Babesiosis in dogs and cats – expanding parasitological and clinical spectra. Vet Parasitol 2011; 181: 48-60
- Solano-Gallego L, Trotta M, Carli E. et al. Babesia canis canis and Babesia canis vogeli clinicopathological findings and detection by means of PCR-RFLP in blood from Italian dogs suspected of tick-borne disease. Vet Parasitol 2008; 157: 211-221
- Zygner W, Gójska-Zygner O, Bąska P, Długosz E. Increased concentration of serum TNF alpha and its correlations with arterial blood pressure and indices of renal damage in dogs infected with Babesia canis. Parasitol Res 2014; 113 (04) 1499-1503
- Zygner W, Gójska-Zygner O. Increased serum urea to creatinine ratio and its negative correlation with arterial pressure in canine babesiosis. Acta Parasitol 2014; 59 (03) 548-551
- Bohm M, Leisewitz AL, Thompson PN, Schoeman JP. Capillary and venous Babesia canis rossi parasitaemias and their association with outcome of infection and circulatory compromise. Vet Parasitol 2006; 141: 18-29
- Ogo N, Okubanjo O, Kamani J. Current Status of Canine Babesiosis and the Situation in Nigeria: A Review. Nigerian Vet J 2011; 32 (02) 69-78
- Globokar Vrhovec M. Retrospektive Analyse der parasitologischen Untersuchungs-ergebnisse eines privaten Untersuchungslabors: Intestinale, respiratorische und vektorübertragene Parasitosen bei Hunden und Katzen in Deutschland (2004 – 2006) [Dissertation]. Giessen: Justus-Liebig-Universität Giessen; 2013
- Jongejan F, Fourie JJ, Chester ST. et al. The prevention of transmission of Babesia canis canis by Dermacentor reticulatus ticks to dogs using a novel combination of fipronil, amitraz and (S)-methoprene. Vet Parasitol 2011; 179: 343-350
- Adaszek Ł, Banach T, Bartnicki M. et al. Application the mass spectrometry MALDI-TOF technique for detection of Babesia canis canis infection in dogs. Parasitol Res 2014; 113 (11) 4293-4295
- Sainz A, Roura X, Miro G. et al. Guideline for veterinary practitioners on canine ehrlichiosis and anaplasmosis in Europe. Parasit Vectors 2015; 8: 75
- Vercammen F, De Deken R, Maes L. Clinical and serological observations on experimental infections with Babesia canis and its diagnosis using the IFAT. Parasite 1995; 2: 407-410
- Fukumoto S, Sekine Y, Xuan X. et al. Serodiagnosis of canine Babesia gibsoni infection by enzyme-linked immunosorbent assay with recombinant P50 expressed in Escherichia coli. J Parasitol 2004; 90: 387-391
- Uilenberg G, Franssen FF, Perie NM, Spanjer AA. Three groups of Babesia canis distinguished and a proposal for nomenclature. Vet Q 1989; 11: 33-40
- Yamane I, Thomford JW, Gardner IA. et al. Evaluation of the indirect fluorescent antibody test for diagnosis of Babesia gibsoni infections in dogs. Am J Vet Res 1993; 54: 1579-1584
- Kovačević Filipović MM, Beletić AD, Ilić Božović AV. et al. Molecular and serological prevalence of Anaplasma phagocytophilum, A. platys, Ehrlichia canis, E. chaffeensis, E. ewingii, Borrelia burgdorferi, Babesia canis, B. gibsoni and B. vogeli among among Clinically Healthy Outdoor Dogs in Serbia. Vet Parasitol Reg Stud Reports 2018; 14: 117-122
- Maggi RG, Birkenheuer AJ, Hegarty BC. et al. Comparison of serological and molecular panels for diagnosis of vector-borne diseases in dogs. Parasit Vectors 2014; 7: 127
- Conrad P, Thomford J, Yamane I. et al. Hemolytic anemia caused by Babesia gibsoni infection in dogs. J Am Vet Med Assoc 1991; 199: 601-605
Teil 2 (ab Diagnostik):
- Zahler M, Rinder H, Schein E. et al. Detection of a new pathogenic Babesia microti-like species in dogs. Vet Parasitol 2000; 89 (03) 241-248
- Zahler M, Rinder H, Zweygarth E. et al. Babesia gibsoni of dogs from North America and Asia belong to different species. Parasitology 2000; 120 (04) 365-369
- Beck R, Vojta L, Mrljak V. et al. Diversity of Babesia and Theileria species in symptomatic and asymptomatic dogs in Croatia. Int J Parasitol 2009; 39 (07) 843-848
- Strobl A, Pantchev N, Martin L. et al. Co-infection with Babesia canis and Babesia gibsoni in a dog. Acta Vet Hung 2021; DOI: 10.1556/004.2021.00048.
- Miro G, Checa R, Paparini A. et al. Theileria annae (syn. Babesia microti-like) infection in dogs in NW Spain detected using direct and indirect diagnostic techniques: clinical report of 75 cases. Parasit Vectors 2015; 8: 217
- Matjila PT, Leisewitz AL, Jongejan F. et al. Molecular detection of tick-borne protozoal and ehrlichial infections in domestic dogs in South Africa. Vet Parasitol 2008; 155: 152-157
- Solano-Gallego L, Capri A, Pennisi MG. et al. Acute febrile illness is associated with Rickettsia spp infection in dogs. Parasit Vectors 2015; 8: 216
- Vercammen F, De Deken R, Maes L. Clinical and serological observations on experimental infections with Babesia canis and its diagnosis using the IFAT. Parasite 1995; 2: 407-410
- Di Cicco MF, Downey ME, Beeler E. et al. Re-emergence of Babesia conradae and effective treatment of infected dogs with atovaquone and azithromycin. Vet Parasitol 2012; 187: 23-27
- Lin EC, Chueh LL, Lin CN. et al. The therapeutic efficacy of two antibabesial strategies against Babesia gibsoni . Vet Parasitol 2012; 186: 159-164
- Vercammen F, De Deken R, Maes L. Prophylactic treatment of experimental canine babesiosis (Babesia canis) with doxycycline. Vet Parasitol 1996; 66: 251-255
- Lin MY, Huang HP. Use of a doxycycline-enrofloxacin-metronidazole combination with/without diminazene diaceturate to treat naturally occurring canine babesiosis caused by Babesia gibsoni . Acta Vet Scand 2010; 52: 27
- Ayoob AL, Hackner SG, Prittie J. Clinical management of canine babesiosis,. J Vet Emerg Crit Care (San Antonio) 2010; 20 (01) 77-89
- Aktas M, Vinclair P, Lefebvre HP. et al. In vivo quantification of muscle damage in dogs after intramuscular administration of drugs. Br Vet J 1995; 151 (02) 189-196
- Grundy SA, Barton C. Influence of drug treatment on survival of dogs with immune-mediated hemolytic anemia: 88 cases (1989–1999). J Am Vet Med Assoc 2001; 218: 543-546
- Scott-Moncrieff JC, Treadwell NG, McCullough SM. et al. Hemostatic abnormalities in dogs with primary immune-mediated hemolytic anemia. J Am Anim Hosp Assoc 2001; 37: 220-227
- Kidd L, Mackman N. Prothrombotic mechanisms and anticoagulant therapy in dogs with immune-mediated hemolytic anemia. J Vet Emerg Crit Care (San Antonio) 2013; 23: 3-13
- Solano-Gallego L, Baneth G. Babesiosis in dogs and cats – expanding parasitological and clinical spectra. Vet Parasitol 2011; 181: 48-60
- Irwin PJ. Canine babesiosis: from molecular taxonomy to control. Parasit Vectors 2009; Suppl 1(Suppl 1): S4
- Bourdoiseau G. Canine babesiosis in France. Vet Parasitol 2006; 138: 118-125
- Eichenberger RM, Riond B, Willi B. et al. Prognostic markers in acute Babesia canis infections. J Vet Intern Med 2016; 30: 174-182
- Brandao LP, Hagiwara MK, Myiashiro SI. Humoral immunity and reinfection resistance in dogs experimentally inoculated with Babesia canis and either treated or untreated with imidocarb dipropionate. Vet Parasitol 2003; 114: 253-265
- Jefferies R, Ryan UM, Jardine J. et al. Blood, Bull Terriers and Babesiosis: further evidence for direct transmission of Babesia gibsoni in dogs. Aust Vet J 2007; 85: 459-463
- Birkenheuer AJ, Levy MG, Breitschwerdt EB. Efficacy of combined atovaquone and azithromycin for therapy of chronic Babesia gibsoni (Asian genotype) infections in dogs. J Vet Intern Med 2004; 18: 494-498
- Birkenheuer AJ. Detection and molecular characterization of a novel large Babesia species in a dog. Vet Parasitol 2004; 124(3 – 4): 151-160
- ESCCAP. Bekämpfung von Ektoparasiten (Flöhe, Zecken, Läuse, Haarlinge, Sand- und Stechmücken) bei Hunden und Katzen. Deutsche Adaption der ESCCAP-Empfehlung Nr. 3, Februar 2022. Im Internet (Stand: August 2022): https://www.esccap.org/uploads/docs/yc6cp5ga_22022EktoparasitenEmpfehlung3.pdf
- Universität Leipzig. Vetidata – Veterinärmedizinischer Informationsdienst für Arzneimittelanwendung, Toxikologie und Arzneimittelrecht in Kooperation mit dem Bundesministerium für Verbraucherschutz und Lebensmittelsicherheit. Im Internet: https://vetidata.de
- Taenzler J, Liebenberg J, Roepke RKA. et al. Prevention of transmission of Babesia canis by Dermacentor reticulatus ticks to dogs treated orally with fluralaner chewable tablets (Bravecto ™). Parasit Vectors 2015; 8: 305-311
- Beck W. Update zur Ektoparasitenbekämpfung. Veterinärspiegel 2021; 31: 56-64
- Halos L, Baneth G, Beugnet F. et al. Defining the concept of ‚tick repellency‘ in veterinary medicine. Parasitol 2012; 139: 419-423
- Eckert J, Deplazes P. Vakzinen gegen Parasiten bei Haustieren. Tierarztl Prax 1996; 24: 322-329
- Moreau Y, Vidor E, Bissuel G. et al. Vaccination against canine babesiosis: an overview of field observations. Trans R Soc Trop Med Hyg 1989; 83 (Suppl) 95-96
- Schetters TP, Kleuskens JA, Scholtes NC. et al. Vaccination of dogs against Babesia canis infection using antigens from culture supernatants with emphasis on clinical babesiosis. Vet Parasitol 1994; 52: 219-233
- Schetters TP, Kleuskens JA, Scholtes NC. et al. Vaccination of dogs against Babesia canis infection. Vet Parasitol 1997; 73: 35-41
- Schetters T. Vaccination against canine babesiosis. Trends Parasitol 2005; 21: 179-184
- Schetters TP, Moubri K, Cooke BM. Comparison of Babesia rossi and Babesia canis isolates with emphasis on effects of vaccination with soluble parasite antigens: a review. J S Afr Vet Assoc 2009; 80: 75-78
- Fukumoto S, Tamaki Y, Okamura M. et al. Primeboost immunization with DNA followed by a recombinant vaccinia virus expressing P50 induced protective immunity against Babesia gibsoni infection in dogs. Vaccine 2007; 25: 1334-1341
- Fukumoto S, Tamaki Y, Igarashi I. et al. Immunogenicity and growth inhibitory efficacy of the prime-boost immunization regime with DNA followed by recombinant vaccinia virus carrying the P29 gene of Babesia gibsoni in dogs. Exp Parasitol 2009; 123: 296-301
- Eckert J, Friedhoff KT, Zahner H, Deplazes P. Lehrbuch der Parasitologie für die Tiermedizin. Stuttgart: Enke; 2005
- Uilenberg G, Verdiesen PA, Zwart D. Imidocarb: a chemoprophylactic experiment with Babesia canis . Vet Q 1981; 3: 118-123
- Vercammen F, De Deken R, Maes L. Clinical and serological observations on experimental infections with Babesia canis and ist diagnosis using the IFAT. Parasite 1995; 2: 407-410
- Wozniak EJ, Barr BC, Thomford JW. et al. Clinical, anatomic, and immunopathologic characterization of Babesia gibsoni infection in the domestic dog (Canis familiaris). J Parasitol 1997; 83: 692-699
- Trotta M, Carli E, Novari G. et al. Clinicopathological findings, molecular detection and characterization of Babesia gibsoni infection in a sick dog from Italy. Vet Parasitol 2009; 165: 318-322
- Boozer L, Macintire D. Babesia gibsoni: An emerging pathogen in dogs. Compendium on Continuing Education for the Practising Veterinarian – North American Edition 2005; 27 (01) 33-42
- Mierzejewska EJ, Welc-Faleciak R, Bednarska M. et al. The first evidence for vertical transmission of Babesia canis in a litter of Central Asian Shepherd dogs. Ann Agric Environ Med 2014; 21 (03) 500-503
- Jeagley TJ, Reichard MV, Hempstead JE. et al. Detection of Babesia gibsoni and the canine small Babesia ‘Spanish isolate’ in blood samples obtained from dogs confiscated from dogfighting operations. J Am Vet Med Assoc 2009; 235: 535-539
- Birkenheuer AJ, Levy MG, Breitschwerdt EB. Efficacy of combined atovaquone and azithromycin for therapy of chronic Babesia gibsoni (Asian genotype) infections in dogs. J Vet Intern Med 2004; 18: 494-498
- Birkenheuer AJ, Levy MG, Stebbins M. et al. Serosurvey of anti-Babesia antibodies in stray dogs and American pit bull terriers and American staffordshire terriers from North Carolina. J Am Anim Hosp Assoc 2003; 39: 551-557
- Springer A, Strube C. Buntzecken in Deutschland. Dt Tierärztebl 2021; 69 (01) 20-23
- Beck S, Schein E, Baldermann C. et al. Zeckeninfestation und Zeckenprophylaxe bei Hunden im Raum Berlin/Brandenburg – Ergebnisse einer Fragebogenstudie. Berl Münch Tierärztl Wochenschr 2013; 126: 69-76



